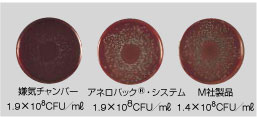
写真：培養結果 Prevotella intermedia

2. 嫌気培養用製品[アネロパック®]
アネロパック®・ケンキ、アネロパウチ®・ケンキは酸素吸収・炭酸ガス発生剤です。
アルミ袋を破って中の白い小袋を容器に入れるだけで、水も触媒も必要ありません。
ジャー用「アネロパック®・ケンキ」
嫌気性菌の培養に。嫌気ジャーまたはWチャック付スタンディングパウチとあわせてご使用ください。
- 発生する炭酸ガス量が多いので、大きなコロニーが得られます
- 特に黒色色素産生グラム陰性桿菌の色素産生量は、他の方法より良好と評価されています(第21、22回嫌気性菌感染症研究会)。
- ジャー内が過度に陽圧・陰圧・高温にならないので角型ジャーを使用でき、フタの開閉も容易に行なえます
- アネロパック®は有機酸を主成分としています
- 容量3.5Lジャー専用のアネロパック®・ケンキ(中/3.5L)もご用意しています。
※表面に黒いシミの出ることがありますが、 性能には支障はありませんのでそのままご使用ください。
|
アネロパック®・ケンキによるガス濃度変化の例
※アネロパック®・ケンキが容器内の酸素を吸収すると同時に、15%以上の炭酸ガスを発生し、嫌気環境を作ります(2時間以内にジャー内の酸素は0.1%以下になります)。 |
アネロパック®・ケンキ10%のガス濃度変化の例
※CO2濃度は10%。薬剤の感受性試験専用。酸素吸収・CO2発生スピードはアネロパック®・ケンキと同一です。 |
|---|
アネロパック®・ケンキ(高温菌用)
嫌気性高温菌の50℃以上での培養に適しています。アネロパック®・ケンキ(高温菌用)は50℃下で、2時間以内に酸素500mlを吸収します。37℃下ではさらに1~2時間程度を要します。
Wチャック付スタンディングパウチもしくはスタンディングパウチと密閉クリップ(高温培養用)をご使用ください。角型ジャーにはご使用になれません。
パウチ袋用「アネロパウチ®・ケンキ」
平板培地2枚での少量培養用。嫌気要求度の低い菌の場合3枚も可能です。
Wチャック袋または専用パウチ袋とご使用ください。
- 平板培地の枚数が少ない場合に最適です
- 検体の輸送用にも有効です
- 菌の発育状態が密閉したままで確認できます。
- 専用パウチ袋は穴が開かない限り、繰り返し使用可能です。


培養結果
|
Prevotella intermedia
|
Finegoldia magna
|
|||
|---|---|---|---|---|
|
Fusobacterium necrophorum
※アネロパック®・ケンキが容器内の酸素を吸収すると同時に、16%以上の炭酸ガスを発生し、嫌気環境を作ります(2時間以内にジャー内の酸素は0.1%以下になります)。 |
OFLX 0.05μg/ml
(写真提供:NTT東日本関東病院・臨床検査部、(株)ビー・エム・エル) |
ご使用にあたって
| アネロパック®・ケンキ | アネロパウチ®・ケンキ | |
|---|---|---|
| 使用量 |
|
|
| 使用上の注意 |
|
|